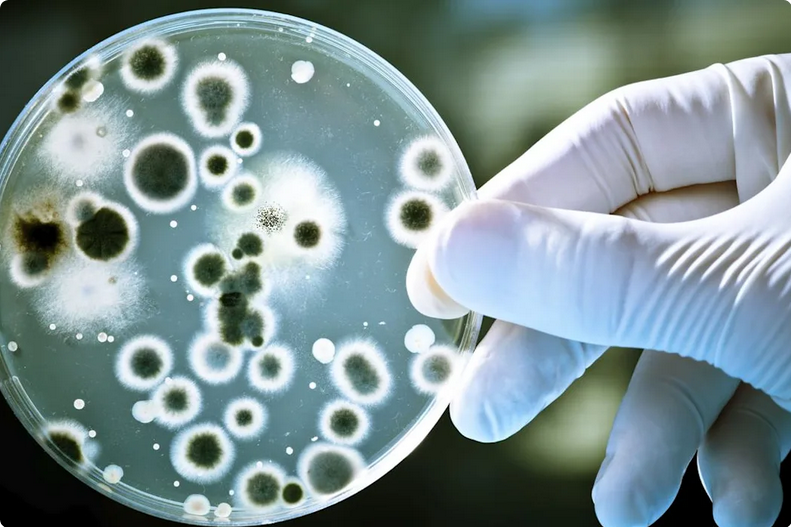

Tin Úc: WHO cảnh báo tình trạng vi khuẩn kháng thuốc đe dọa sức khỏe trẻ em
10:00' 24-10-2025
Tổ chức Y tế Thế giới (WHO) vừa công bố báo cáo cho thấy các ca nhiễm khuẩn kháng kháng sinh đang gia tăng nhanh trên toàn cầu, vì cứ khoảng sáu ca nhiễm khuẩn phổ biến trong năm 2023 thì có một ca không còn đáp ứng điều trị bằng thuốc kháng sinh.
Picture: iStock
Báo cáo cảnh báo các loại thuốc thiết yếu đang mất tác dụng trước những vi khuẩn nguy hiểm như E. coli, Salmonella và các vi khuẩn gây viêm màng não, viêm phổi hoặc nhiễm trùng đường tiểu. Dù tình hình ở Úc ít nghiêm trọng hơn, giới chuyên gia cho biết tỷ lệ kháng thuốc vẫn đáng lo ngại. Bác sĩ Trent Yarwood, thành viên Hiệp hội Các bệnh truyền nhiễm Úc, cho biết ở một số khu vực trên thế giới, có đến một phần ba các ca nhiễm trùng không đáp ứng với thuốc kháng sinh thông thường, khiến nhiều người phải nhập viện điều trị thay vì chỉ cần uống thuốc như trước.
Hãng tin Yahoo News cho biết, tại Úc, báo cáo ghi nhận tỷ lệ vi khuẩn kháng thuốc ở trẻ em vẫn thấp hơn mức trung bình toàn cầu, song vẫn là mối nguy hiểm đáng chú ý.
Nhà dịch tễ học Anita Williams thuộc Viện Nghiên cứu Trẻ em Úc cho biết, trong năm 2022–2023, 40% vi khuẩn gây nhiễm trùng máu ở trẻ em Úc kháng thuốc, và 10% trong số đó kháng với ít nhất ba nhóm kháng sinh khác nhau. Cụ thể, vi khuẩn E. coli kháng thuốc ở mức 21.5% tại Úc so với 45% trên thế giới; còn nhiễm khuẩn Staphylococcus kháng thuốc ở mức 13.6% tại Úc, thấp hơn nhiều so với 27.1% toàn cầu.
WHO cảnh báo khả năng kháng thuốc đang vượt xa tiến bộ y học hiện nay, đồng thời kêu gọi mọi người chỉ sử dụng kháng sinh khi thật sự cần thiết, duy trì vệ sinh, tiêm chủng và an toàn thực phẩm để ngăn chặn nguy cơ lây nhiễm và bảo vệ sức khỏe trẻ em.
Hong Dao - Viet Times Australia (Published by Adpro Media P/L)

Bạn đang tìm dịch vụ về Tiệm rượu?
Tiệm rượu với đầy đủ các lựa chọn về rượu, bia nhiều nhất tại vùng Springvale
Article sourced from au.news.yahoo.com.
